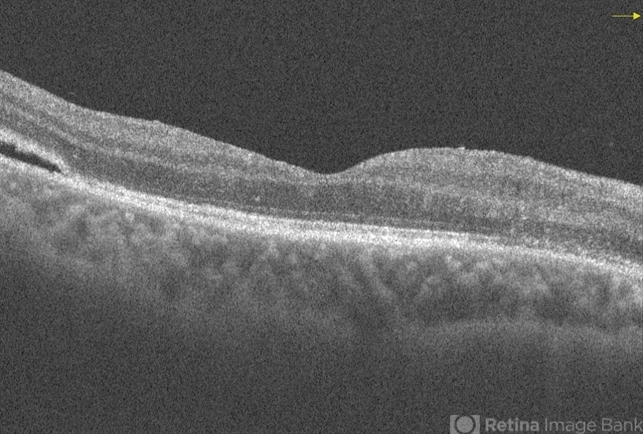

-
 By Ogugua Ndubuisi Okonkwo, MD, FRCS (Edin), FASRS
By Ogugua Ndubuisi Okonkwo, MD, FRCS (Edin), FASRS
Eye Foundation Retina Institute
Co-author(s): Adekunle Hassan, Eye Foundation Hospital, Lagos - Uploaded on Sep 14, 2021.
- Last modified by Jennifer Carstens on Sep 14, 2021.
- Rating
- Appears in
- Miscellaneous
- Condition/keywords
- re-attached retinal detachment (RRD), subretinal fluid
- Photographer
- Oreoluwa , Eye Foundation Hospital, Lagos
- Imaging device
-
Optical coherence tomography system
Optovue Avanti RTVue - Description
- Postoperative Optical Coherence Tomography (OCT) of the right eye of a 35-year-old male showing persistence of subretinal fluid in the original area of the retinal detachment.

Initializing download.
Initializing download.






